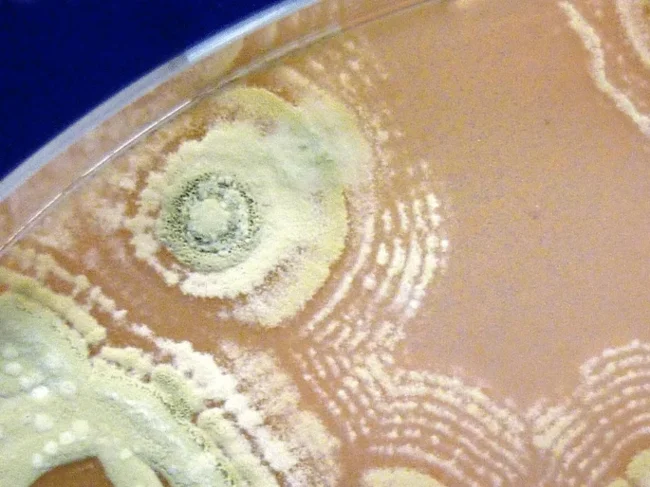

Целебная земля Бохо: от древнего поверья к научному открытию (9 фото)
На нагорье Бохо в Северной Ирландии уже более двух веков передают историю о земле, способной исцелять болезни. В 1815 году здесь был похоронен священник Джеймс МакГирр, при жизни славившийся даром врачевания. По преданию, перед смертью он сказал пастве: «Глина, что покроет меня, будет лечить всё, что я исцелял при жизни». 
С тех пор среди местных жителей сложился особый ритуал. Больные приходили на могилу МакГирра, брали ложку земли, заворачивали её в холщовый мешочек и клали под подушку. Считалось, что уже к утру недуг отступал. После выздоровления землю обязательно возвращали на кладбище, иначе человека ждали неудачи.
Между верой и наукой 
Приходское кладбище в Бохо, где покоится священник-целитель Джеймс МакГирр
Для одних это просто суеверие, для других — непреложная истина. Но нашлись и те, кто решил проверить легенду. Среди них микробиолог Джерри Куинн, выросший в этих местах. 
Образцы почвы, взятые с кладбища церкви Бохо
Сначала он скептически относился к этому народному средству, но при этом понимал: если традиция живёт так долго, в ней может быть доля правды. 
Надгробие с табличками о «благословенной глине»
В 2018 году он с коллегами из Медицинской школы Университета Суонси исследовал образцы почвы с кладбища Бохо. Оказалось, «чудо» объяснялось не божественным вмешательством, а деятельностью крошечных организмов — бактерий Streptomyces. 
Ложка земли с могилы МакГирра
Земля эта действительно особенная. На это влияют такие факторы как уникальный штамм (в почве обнаружили ранее неизвестный вид Streptomyces, способный убивать даже устойчивые к антибиотикам бактерии) и щелочная среда. Грунт Бохо сформировался на известняковой породе, что придало ему высокую щёлочность, а это идеальные условия для производства антибиотиков. При этом Streptomyces не могут двигаться, поэтому вырабатывают мощные антибиотики, чтобы защитить свою территорию от других микробов. 
Предупреждение от приходского священника: «Образцы земли необходимо вернуть на четвёртый день»
В образцах из Бохо нашли 8 штаммов Streptomyces, каждый из которых производит 10–20 разных антибиотиков. 
Микробиолог Джерри Куинн
Это потенциально около сотни новых соединений. Теперь нужно идентифицировать их и провести клинические испытания. Открытие особенно актуально сегодня, когда ВОЗ предупреждает, что к 2050 году устойчивые к лекарствам бактерии могут убивать 1,3 миллиона человек в год только в Европе.
Streptomyces
Легенда о земле Бохо, которую столетия считали просто народным поверьем, оказалась научным фактом. А могила священника МакГирра, ставшая местом паломничества, теперь привлекает и исследователей, ищущих новые способы борьбы с супербактериями. 
В малонаселённых районах высокогорья Бохо на щелочных почвах, образованных из известняка, обитают редкие микробы, ожидающие своего открытия






























